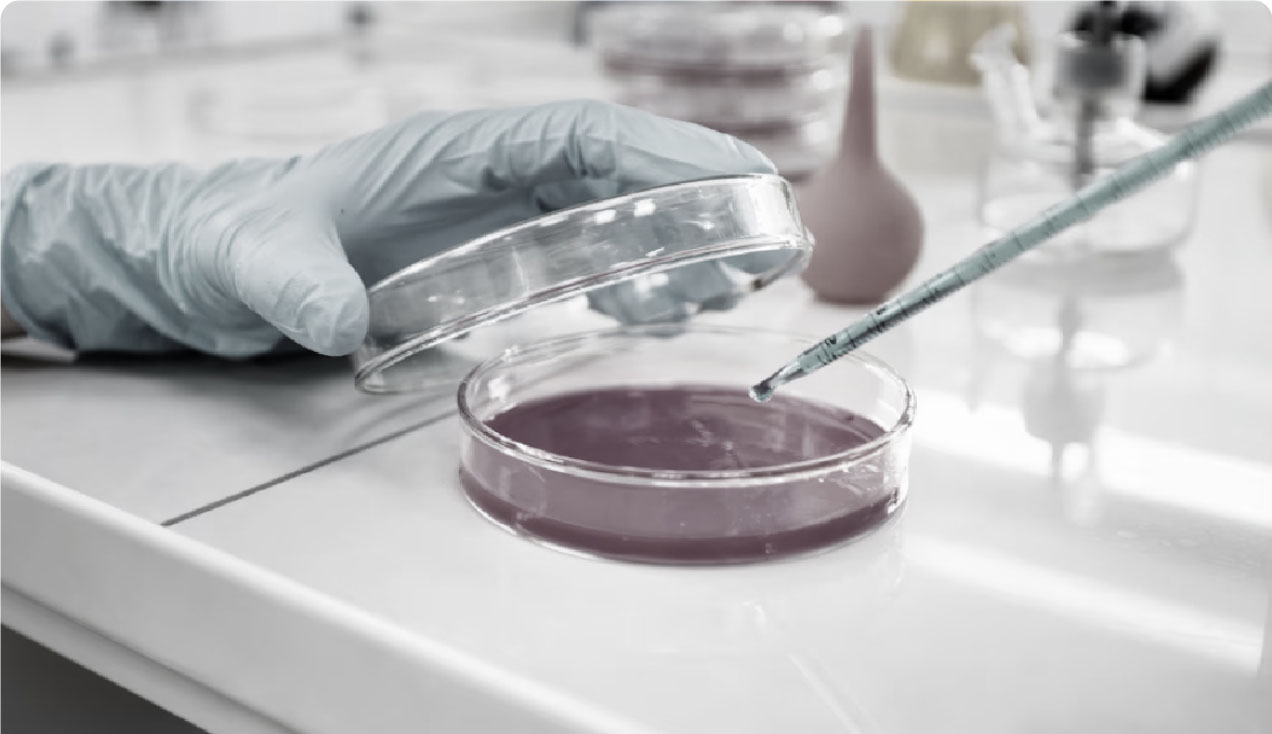

+15 años en el mercado fabricando, maquilando y distribuyendo productos cosméticos.
Innova con nosotros
Desarrollo de fórmulas
Nos especializamos en desarrollar fórmulas cosméticas innovadoras y altamente eficientes que redefinen el cuidado personal. Combinamos ciencia, creatividad y tecnología avanzada para ofrecer productos que no solo marcan tendencia, sino que también brindan resultados visibles y duraderos, cuidando de ti y del planeta.
Saber más
Maquila
Ofrecemos el servicio de maquila de productos cosméticos faciales, corporales y capilares, respaldado por una alta capacidad productiva. Gracias a nuestra avanzada tecnología, un equipo altamente capacitado y procesos automatizados, garantizamos eficiencia, calidad y personalización en cada proyecto, llevando tus ideas al siguiente nivel.
Saber más¿Por qué elegirnos?
Innovación constante
Diseñamos y fabricamos productos cosméticos disruptivos que destacan por su eficiencia y originalidad. Viajamos por el mundo explorando nuevos componentes, estudiando el mercado y analizando las tendencias para comprender a profundidad las necesidades de los consumidores, creando soluciones únicas que se adaptan y transforman el mercado.
Clean Beauty
Utilizamos ingredientes de origen orgánico y natural, respaldados por estudios científicos para garantizar la máxima eficacia en nuestras formulaciones. Nos comprometemos con el cuidado del planeta mediante prácticas sostenibles, alineándonos con la filosofía de Clean Beauty, para ofrecer productos efectivos que respetan tanto a las personas como al medio ambiente.
Alta capacidad productiva
Contamos con tecnología de última generación, procesos automatizados y un equipo experto, lo que nos permite garantizar rapidez, calidad y escalabilidad en la producción.
Acompañamiento y soporte
Capacitamos a todo su equipo, ofreciendo un servicio de postventa excelente para maximizar el impacto y éxito de sus productos.








